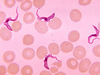

Chapter 12 Flashcards
(86 cards)
What % of the world’s population is infected with eukaryotic pathogens
50%
Name 7 common eukaryotic pathogens “CCHAMPS”
Cryptosporidium
Cyclospora
hookworm
amebiasis
malaria
Pneumocystis (AIDS)
shistosomiasis
How do we benefit from fungi?
bread, beer, penicillin
What is Mycology
the study of fungi
True or False: Yeast is part of the normal skin flora?
True
How many species of fungi are pathogenic?
about 200 of 100,000
How are decomposing fungi helpful?
They recycle nutrients in the soil
Humans exploit fungi for __________ and medical purposes. (fill in blank)
food
What is a chemoheterotroph?
organism that acquire carbon and nrg from organic compounds
Are fungi unicellular, multicellular or both?
Both
What are fungal cell walls composed of?
Chitin
Do fungi tolerate a low or high pH?
Lower. Approx. 5
What do fungi have that help in digesting hard parts of plants?
Cellulases
Facultative anaerobic fungi are called ___________?
Yeasts
Are fungi photosynthetic?
No
True or False: Fungi are anaerobic…
False. Very few are anaerobic.
Why are fungal infections more difficult to treat?
B/c they are more similar to human cells than bacterial cells.
Fill in the blank for FUNGI:
- Cell Type ______________
- Cell Membrane _______________
- Cell Wall ______________
- Spores ______________
- Metabolism ___________________
- Eukaryotic
- Sterols present
- Glucans; mannans; chitin (no peptidoglycan)
- Sexual and asexual reproduction
- Limited to heterotrophic; aerobic, facultatively anaerobic
Fill in the blank for BACTERIA:
- Cell Type ______________
- Cell Membrane _______________
- Cell Wall ______________
- Spores ______________
- Metabolism ___________________
- Prokaryotic
- Sterols absent, excepts in Mycoplasma
- Peptidoglycan
- Endospores (not for reproduction); some asexual reproductive spores
- Heterotrophic, autotrophic; aerobic, facultatively anaerobic, anaerobic
How are Multicellular fungi identified/classified?
On the basis of physical appearance
Fungal colonies are described as _______________ structures
Vegetative
The __________ is the body of a mold or fleshy fungus that is composed of filaments, or hyphae.
thallus
What are hyphae?
Filaments that grow by elongation at the tips.
Vegetative hyphae form _________________, and are involved in ________bolism and growth.
mycelium, cata…